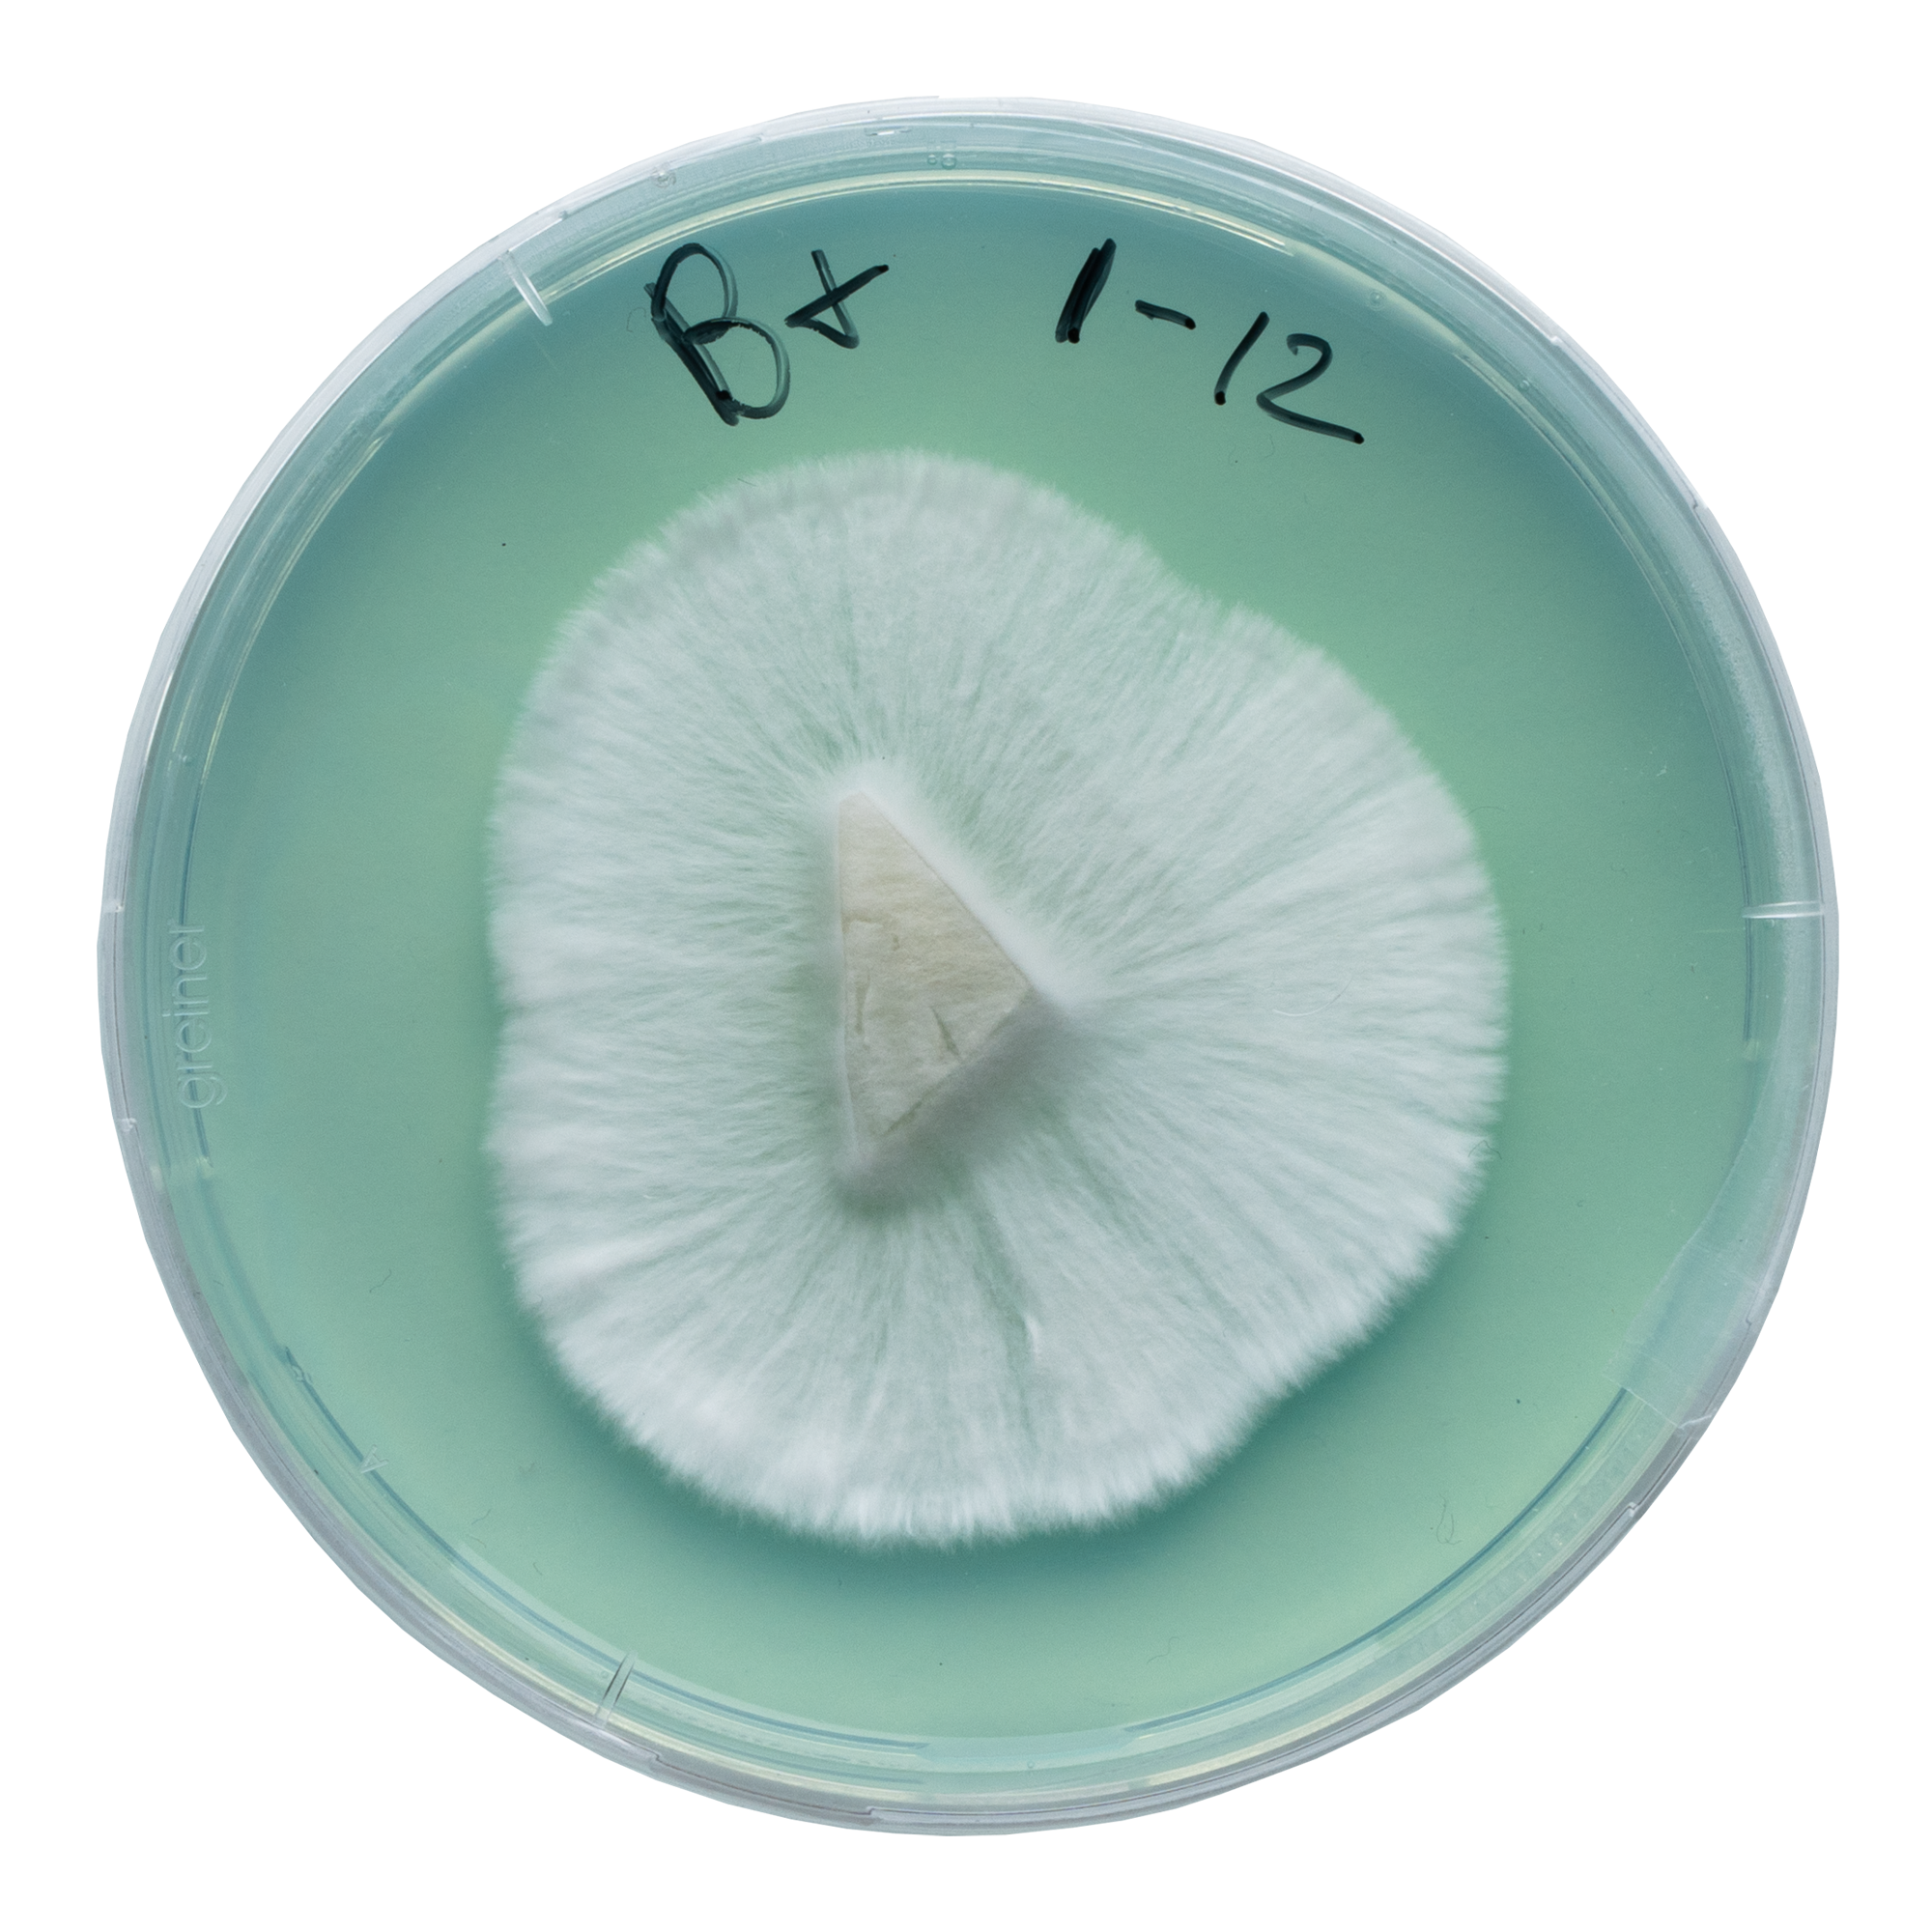
acid shroomz b+ b positive agar magic mushrooms

B+ paddo’s: oorsprong en genetica
Naar verluidt is de B+ in de jaren 90 ontwikkeld of ontdekt door Mister G, een sporendistributeur die destijds in Florida zou zijn gevestigd. Hij zou de sporen verder in de community hebben verspreid. Om het verhaal nog wat spannender te maken gaan er zelfs geruchten dat de B+ een kruising zou zijn van Psilocybe cubensis en Psilocybe azurescens. Het is echter zeer goed mogelijk dat dit überhaupt niet mogelijk is.
Waar wel echter wel zeker van kunnen zijn, is dat de B+ een ontzettend populaire en veelzijdige Psilocybe cubensis soort is. Dit komt onder andere doordat deze soort het vermogen heeft om onder minder ideale omstandigheden te groeien. Hierdoor is het een uitstekende keuze voor zowel beginnende als ervaren kwekers. Daarnaast kun je met de juiste zorg en omstandigheden rekenen op hoge opbrengsten en meerdere flushes.
Qua uiterlijk hebben B+ paddo’s stevige, witte stengels die snel blauw worden bij aanraking en verwerking. Dit duidt meestal op een gemiddeld tot hoog gehalte psilocybine en psilocine. Bovendien worden hun grote, karamel- tot goudbruine hoeden vaak enkele centimeters in diameter, waardoor ze er visueel aantrekkelijk uitzien.
Met een gemiddelde potentie biedt B+ een aangename maar impactvolle ervaring, ideaal voor wie op zoek is naar een makkelijke introductie tot paddo’s. Haar veerkracht en kweekgemak maken haar tot een favoriet onder kwekers wereldwijd.
Acid Shroomz B+ liquid culture ontwikkeling
De B+ was de allereerste soort die we hebben geïsoleerd en was een een hoeksteen in ons ontwikkelingsproces. We begonnen het isolatieproces met een B+ sporen afdruk, waarvan we de sporen lieten ontkiemen op agarplaten. Kort hierna name we de eerste mycelium groei waar en begon de ontwikkeling van enkele kolonies.
Door middel van meerdere agar transfers isoleerden we de sterkste groei verder en bereikte de cultuur uiteindelijk consistentie en zuiverheid, wat bleek uit zijn uniforme groeipatronen. De resulterende cultuur hebben we vervolgens intensief getest op prestaties zoals groeisnelheid, opbrengst en weerstand tegen besmetting.
Al deze inspanningen hebben geleid tot een zuivere cultuur die uitzonderlijke resultaten kan leveren en is nu beschikbaar via onze B+ liquid culture spuiten zodat iedereen met gemak en op zijn eigen manier B+ paddo’s kan kweken.
Productinhoud
Elke B+ spuit bevat 20 ml levend mycelium in een zorgvuldig samengestelde voedingsoplossing. De spuit is een B. Braun-model van hoge kwaliteit voor nauwkeurige hantering en inoculatie.
Daarnaast bevat de productverpakking twee 70% isopropylalcohol doekjes, een steriele 16G injectienaald en een bijsluiter.
Hoe gebruik je een B+ liquid culture spuit
Bekijk voor meer informatie onze artikelen over het gebruik van liquid culture spuiten.
Veiligheidsmaatregelen en gebruik
Bij het gebruik van de B+ liquid culture spuit is het cruciaal om de juiste veiligheidsmaatregelen te nemen om besmetting te voorkomen en een succesvol groeiproces te garanderen. Hier zijn enkele algemene richtlijnen om in gedachten te houden:
- Gebruik de spuit altijd in een schone en steriele omgeving.
- Draag poedervrije nitril handschoenen en een mondkapje om besmetting te voorkomen.
- Zorg ervoor dat er weinig tot geen luchtstroom is op je werkplek.
- Raak de naald of de liquid culture niet rechtstreeks aan om steriliteit te behouden.
- Bewaar de spuit in de koelkast bij 4-7°C om de houdbaarheid te verlengen.
Optionele accessoires
Overweeg het gebruik van een flow hood of een still air box(SAB) voor extra steriliteit tijdens het enten van substraten.
Algemene gegevens
| Soort | Psilocybe cubensis |
| Genetica | Onbekend |
| Sporen | Donkerpaars tot bruin |
| Toepassingen | Microscopie, onderzoek en taxonomie. |
| Vaardigheidsniveau | Beginner |
| Kolonisatie snelheid | Snel |
| Potentie | Medium |
Teeltgegevens
| Broedfase | |
| Geschikte substraten | Gesteriliseerde granen zoals zilvervliesrijst, rogge, haver, gierst, mais of wild vogelzaad. |
| Kolonisatie tijd | 9-14 dagen (2/3 gevulde liter pot / 27°C / geschud bij 25-33% kolonisatie). |
| Temperatuur | 25-27°C |
| Licht | Weinig licht of duisternis. |
| Vruchtvormende fase | |
| Geschikte substraten | Mest, kokos, CVG of stro (voldoende gehydrateerd en warmtebehandeld). |
| Temperatuur | 21-25°C |
| Relatieve luchtvochtigheid | 80-100% |
| Luchtverversing (FAE) | Zorg voor een goede luchtstroom zonder dat het substraat uitdroogt. |
| Licht | Indirect daglicht of zacht kunstlicht (ongeveer 6500 Kelvin). |
Opmerkingen
Dit product is beperkt houdbaar en kan niet worden geretourneerd. Zie voor meer informatie onze pagina over bedenktijd en retouren.

Beoordelingen
Er zijn nog geen beoordelingen